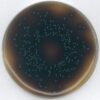

| Tên sản phẩm: | Methyl octanoate for synthesis Merck |
| Tên gọi khác: | Methyl caprylate, Este metyl axit Octanoic , Este metyl axit Caprylic, Methyl capryit |
| Công thức hóa học: | C9H18O2 |
| CAS: | 111-11-5 |
| Code: | 8149270025 |
| Hàm lượng: | ≥ 99,0% |
| Hãng- Xuất xứ: | Merck – Đức |
| Ứng dụng: |
Methyl octanoate để tổng hợp, chất trung gian cho chất tẩy rửa axit caprylic chất nhũ hóa, chất làm ướt, chất ổn định, chất hóa dẻo nhựa, chất bôi trơn, hương liệu. |
| Tính chất: |
– Khối lượng phân tử: 158,24 g/mol – Điểm sôi: 193 °C (1013 hPa) – Tỉ trọng: 0.877 g/cm3 (20 °C) – Điểm sáng: 68 °C – Độ nóng chảy: -40 °C – Áp suất hơi: 1,33 hPa (34,2 °C) – Độ hòa tan: 0,064 g/l – Methyl octanoate dạng chất lỏng không màu. Không hòa tan trong nước. |
| Bảo quản: | Lưu trữ dưới + 30 °C. |
Sản phẩm tham khảo:
| Code sản phẩm | Quy cách đóng gói |
| 8149270025 | Chai thủy tinh 25 ml |
| 8149270100 | Chai thủy tinh 100 ml |

Đánh giá
Chưa có đánh giá nào.